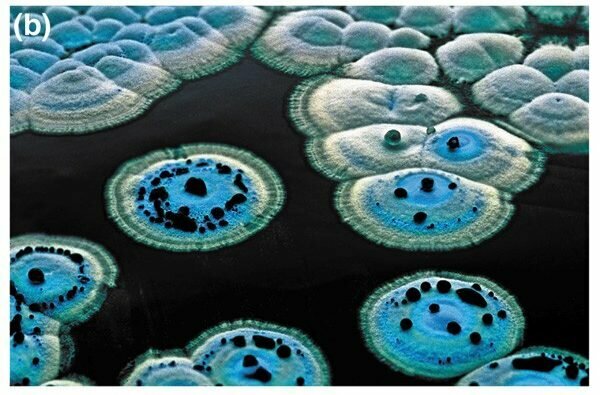
Secuenciación el genoma de la bacteria Streptomyces coelicolor.

-
 El Colera es una diarrea infecciosa aguda producida por Vibrio cholerae. La transmisión se produce predominantemente a través de agua o alimentos contaminados. En el año 2000 se publico la determinación y análisis de la secuencia genomica completa de V. cholerae El Tor (40). El genoma consiste en dos cromosomas circulares de 2.961.146 pb (cromosoma 1) y 1.072.314 pb (cromosoma 2). http://ve.scielo.org/scielo.php?script=sci_arttext&pid=S0798-04772009000200006
El Colera es una diarrea infecciosa aguda producida por Vibrio cholerae. La transmisión se produce predominantemente a través de agua o alimentos contaminados. En el año 2000 se publico la determinación y análisis de la secuencia genomica completa de V. cholerae El Tor (40). El genoma consiste en dos cromosomas circulares de 2.961.146 pb (cromosoma 1) y 1.072.314 pb (cromosoma 2). http://ve.scielo.org/scielo.php?script=sci_arttext&pid=S0798-04772009000200006 -
 Tipo de encefalopatía espongiforme aparece de forma espontánea o por herencia genética. El mal de las vacas locas y la enfermedad que el consumo de su carne produce en las personas pertenecen al grupo de enfermedades llamado encefalopatías espongiformes transmisibles. Producidas por la acción de una proteína prión cuya forma se altera.
Tipo de encefalopatía espongiforme aparece de forma espontánea o por herencia genética. El mal de las vacas locas y la enfermedad que el consumo de su carne produce en las personas pertenecen al grupo de enfermedades llamado encefalopatías espongiformes transmisibles. Producidas por la acción de una proteína prión cuya forma se altera.
https://cuidateplus.marca.com/enfermedades/raras/creutzfeldt-jakob.html
https://www.youtube.com/watch?v=R7gxQlpYGnQ -
Se trata de un microorganismo a partir del cual se producen antibióticos naturales, por lo que el avance puede suponer un importante paso para la producción de nuevos fármacos.
Se trata de un microorganismo a partir del cual se producen antibióticos naturales, por lo que el avance puede suponer un importante paso para la producción de nuevos fármacos.
https://www.intramed.net/contenidover.asp?contenidoid=18749
https://cordis.europa.eu/article/id/32394-bacterial-genome-mining-brings-novel-antibiotic-to-light/es -
 Apareció por primera vez en el sureste de China en Noviembre del año 2002. La primera notificación fue en Asia el 26 de febrero de 2003, por parte del Dr. Carlo Urbani de la OMS, quien la diagnosticó en un hombre de negocios de 48 años que había viajado desde la provincia de Guangdong en China, a través de Hong Kong, hasta Hanoi, en Vietnam y quien murió a causa de dicha enfermedad.
Apareció por primera vez en el sureste de China en Noviembre del año 2002. La primera notificación fue en Asia el 26 de febrero de 2003, por parte del Dr. Carlo Urbani de la OMS, quien la diagnosticó en un hombre de negocios de 48 años que había viajado desde la provincia de Guangdong en China, a través de Hong Kong, hasta Hanoi, en Vietnam y quien murió a causa de dicha enfermedad.
https://fundacionio.com/salud-io/enfermedades/virus/sars-sindrome-agudo-respiratorio-severo/ -
 El virus de la influenza aviar A(H5N1) altamente patógeno (HPAI) de origen asiático se da principalmente en aves y es sumamente contagioso.Desde su reaparición generalizada en 2003.
El virus de la influenza aviar A(H5N1) altamente patógeno (HPAI) de origen asiático se da principalmente en aves y es sumamente contagioso.Desde su reaparición generalizada en 2003.
https://espanol.cdc.gov/flu/avianflu/h5n1-virus.htm
https://www3.paho.org/hq/index.php?option=com_content&view=article&id=2942:2010-influenza-aviar-preguntas-mas-frecuentes&Itemid=569&lang=es -
 La legionelosis, que incluye a la enfermedad del legionario y la fiebre de Pontiac, es una enfermedad respiratoria causada por un tipo de bacteria llamado Legionella.
La legionelosis, que incluye a la enfermedad del legionario y la fiebre de Pontiac, es una enfermedad respiratoria causada por un tipo de bacteria llamado Legionella.
https://higieneambiental.com/aire-agua-legionela/la-genetica-utilizada-para-poder-identificar-y-controlar-las-fuentes-de-los-brotes-de-legionelosis
https://www.cdc.gov/legionella/about/history-sp.html -
 Se secuencia el genoma del Saccharopolyspora erythraea, el microorganismo productor del antibiótico eritromicina.
Se secuencia el genoma del Saccharopolyspora erythraea, el microorganismo productor del antibiótico eritromicina.
https://www.sutori.com/item/2007-se-secuencia-el-genoma-del-saccharopolyspora-erythraea-el-microorganismo-p -
 En 2009 apareció una influenza que causó alarma en los sistemas de salud, porque se trata de una combinación de una cepa totalmente nueva (Garten et al., 2009; Dawood et al., 2009). En marzo de ese año7, tanto en México como en Estados Unidos se detectaron casos de neumonía atípicos.
En 2009 apareció una influenza que causó alarma en los sistemas de salud, porque se trata de una combinación de una cepa totalmente nueva (Garten et al., 2009; Dawood et al., 2009). En marzo de ese año7, tanto en México como en Estados Unidos se detectaron casos de neumonía atípicos.
http://www.scielo.org.mx/scielo.php?script=sci_arttext&pid=S1607-050X2010000100004 -
 Científicos de Suecia han descubierto que un tipo de micobacteria, del género responsable de la tuberculosis, la lepra y la úlcera de Buruli, logra afianzarse en el organismo gracias en parte a su capacidad para formar esporas durante su estado latente.
Científicos de Suecia han descubierto que un tipo de micobacteria, del género responsable de la tuberculosis, la lepra y la úlcera de Buruli, logra afianzarse en el organismo gracias en parte a su capacidad para formar esporas durante su estado latente.
http://biosalud.ucaldas.edu.co/downloads/Biosalud18(1)_7.pdf
https://cordis.europa.eu/article/id/30887-discovery-of-mycobacteria-spore-formation-sheds-light-on-tuberculosis/es -
 Los resultados de investigaciones realizadas con la bacteria Bacillus subtilis han vertido algo de luz en una gran cuestión pendiente sobre la evolución: cómo actúa ésta para que una especie pase de un estado fisiológico concreto a otro. ¿Cómo pasa una especie de insectos de tener dos alas a tener tres, por ejemplo? https://bit.ly/34jVQhq
Los resultados de investigaciones realizadas con la bacteria Bacillus subtilis han vertido algo de luz en una gran cuestión pendiente sobre la evolución: cómo actúa ésta para que una especie pase de un estado fisiológico concreto a otro. ¿Cómo pasa una especie de insectos de tener dos alas a tener tres, por ejemplo? https://bit.ly/34jVQhq
https://bit.ly/3o6FQGk -
 La reutilización de las pinzas ópticas como un nanomicrófono un millón de veces más sensible que el oído humano permite pensar que pronto tendremos un sistema para oír a las bacterias.
La reutilización de las pinzas ópticas como un nanomicrófono un millón de veces más sensible que el oído humano permite pensar que pronto tendremos un sistema para oír a las bacterias.
https://universitam.com/academicos/noticias/logran-inventar-ya-el-nanomicrofono/ -
 El MERS es causado por el coronavirus del síndrome respiratorio de Oriente Medio (MERS-CoV, por sus siglas en inglés). Los Coronavirus son una familia de virus que pueden causar infecciones respiratorias leves a graves. Se reportó por primera vez en Arabia Saudita en 2012 y luego se propagó a otros países. La mayoría de los casos se propagaron a partir de personas que viajaron a países de Oriente Medio.
El MERS es causado por el coronavirus del síndrome respiratorio de Oriente Medio (MERS-CoV, por sus siglas en inglés). Los Coronavirus son una familia de virus que pueden causar infecciones respiratorias leves a graves. Se reportó por primera vez en Arabia Saudita en 2012 y luego se propagó a otros países. La mayoría de los casos se propagaron a partir de personas que viajaron a países de Oriente Medio.
https://medlineplus.gov/spanish/ency/patientinstructions/000723.htm -
 La prueba de Ames, también llamada las salmonelas prueba, es un análisis bacteriano a corto plazo usado para determinar las substancias que causan mutaciones de gen.
La prueba de Ames, también llamada las salmonelas prueba, es un análisis bacteriano a corto plazo usado para determinar las substancias que causan mutaciones de gen.
https://www.news-medical.net/life-sciences/The-Ames-Test-(Spanish).aspx -
 Los investigadores del MIT han demostrado ahora que estos circuitos pueden aislarse dentro de las «células» sintéticas individuales, evitando que se interrumpan entre sí. Los investigadores también pueden controlar la comunicación entre estas células, permitiendo que los circuitos o sus productos se combinen en momentos específicos.
Los investigadores del MIT han demostrado ahora que estos circuitos pueden aislarse dentro de las «células» sintéticas individuales, evitando que se interrumpan entre sí. Los investigadores también pueden controlar la comunicación entre estas células, permitiendo que los circuitos o sus productos se combinen en momentos específicos.
https://universitam.com/academicos/noticias/investigadores-del-mit-crean-celulas-sinteticas-para-aislar-circuitos-geneticos/ -
 Un equipo científico ha descubierto la bacteria Thiolava veneris en el volcán submarino Tagoro, que se creó a raíz de la erupción volcánica en la isla canaria de El Hierro, entre finales de 2011 e inicios de 2012. Esta comunidad bacteriana, encontrada a 130 metros de profundidad, forma un extenso tapiz microbiano de filamentos, llamados cabello de Venus, cerca de la cima del Tagoro.
Un equipo científico ha descubierto la bacteria Thiolava veneris en el volcán submarino Tagoro, que se creó a raíz de la erupción volcánica en la isla canaria de El Hierro, entre finales de 2011 e inicios de 2012. Esta comunidad bacteriana, encontrada a 130 metros de profundidad, forma un extenso tapiz microbiano de filamentos, llamados cabello de Venus, cerca de la cima del Tagoro.
https://universitam.com/academicos/noticias/emerge-nueva-bacteria-luego-de-erupcion-del-volcan-submarino-tagoto/ -
 «Este descubrimiento revela cómo la evolución rápida ocurre en algunos organismos más pequeños y más comunes, sin embargo, menos conocidos, los microbios de la Tierra», dijo Mike Sieracki de la División de Ciencias del Mar y director del programa en la Fundación Nacional de Ciencia (NSF) del programa de biodiversidad, que apoyó la investigación.
«Este descubrimiento revela cómo la evolución rápida ocurre en algunos organismos más pequeños y más comunes, sin embargo, menos conocidos, los microbios de la Tierra», dijo Mike Sieracki de la División de Ciencias del Mar y director del programa en la Fundación Nacional de Ciencia (NSF) del programa de biodiversidad, que apoyó la investigación.
https://universitam.com/academicos/noticias/descubren-microorganismos-que-auto-mutan-mas-pequenos-que-bacterias-y-abundantes-en-el-planeta/ -
 Un equipo de investigadores dirigido por el profesor Jay Hinton de la Universidad de Liverpool ha identificado un cambio genético específico, o polimorfismo de nucleótido único (SNP), que ayuda a la salmonela africana a sobrevivir en el torrente sanguíneo humano.
Un equipo de investigadores dirigido por el profesor Jay Hinton de la Universidad de Liverpool ha identificado un cambio genético específico, o polimorfismo de nucleótido único (SNP), que ayuda a la salmonela africana a sobrevivir en el torrente sanguíneo humano.
https://bit.ly/3IJHTbt -
 Científicos del Imperial College London se han convertido en los primeros en el mundo en probar cómo los patógenos interactúan con los órganos humanos artificiales.
Científicos del Imperial College London se han convertido en los primeros en el mundo en probar cómo los patógenos interactúan con los órganos humanos artificiales.
https://bit.ly/3uaoTim -
 Fue reportado por primera vez el martes 7 de enero de 2020, por el CDC de China (Centro para el Control y la Prevención de Enfermedades), luego de que el 31 de diciembre de 2019 la Comisión de Salud Municipal de la ciudad de Wuhan en la provincia de Hubei, notificara 27 casos de un tipo de neumonía de etiología desconocida, siete de los cuales eran severos.
Fue reportado por primera vez el martes 7 de enero de 2020, por el CDC de China (Centro para el Control y la Prevención de Enfermedades), luego de que el 31 de diciembre de 2019 la Comisión de Salud Municipal de la ciudad de Wuhan en la provincia de Hubei, notificara 27 casos de un tipo de neumonía de etiología desconocida, siete de los cuales eran severos.
https://policlinicametropolitana.org/informacion-de-salud/el-nuevo-coronavirus-que-es-donde-surgio-y-como-protegerse/ -
 Esta y otras vacunas han cumplido los rigurosos estándares científicos de la FDA para la autorización de uso de emergencia, al ser la primera vacuna contra el COVID-19 aprobada por la FDA, el público puede estar muy seguro de que esta vacuna cumple con los altos estándares de seguridad, eficacia y calidad de fabricación que la FDA exige para un producto aprobado
Esta y otras vacunas han cumplido los rigurosos estándares científicos de la FDA para la autorización de uso de emergencia, al ser la primera vacuna contra el COVID-19 aprobada por la FDA, el público puede estar muy seguro de que esta vacuna cumple con los altos estándares de seguridad, eficacia y calidad de fabricación que la FDA exige para un producto aprobado
https://www.fda.gov/news-events/press-announcements/la-fda-aprueba-la-primera-vacuna-contra-el-covid-19 -
 Gracias al sistema CRISPR-Cas9, científicos de la Universidad de Manchester han conseguido modificar proteínas complejas para generar potenciales moléculas antibióticas complicadas de crear en el laboratorio.
Gracias al sistema CRISPR-Cas9, científicos de la Universidad de Manchester han conseguido modificar proteínas complejas para generar potenciales moléculas antibióticas complicadas de crear en el laboratorio.
https://www.investigacionyciencia.es/noticias/desarrollan-un-mtodo-novedoso-para-crear-nuevos-antibiticos-gracias-a-la-edicin-gentica-20567 -
 Investigadores del Instituto de Bioingeniería de Cataluña han diseñado un nuevo dispositivo para estudiar la formación de biofilms bacterianos y evaluar su susceptibilidad a los antibióticos.
Investigadores del Instituto de Bioingeniería de Cataluña han diseñado un nuevo dispositivo para estudiar la formación de biofilms bacterianos y evaluar su susceptibilidad a los antibióticos.
https://www.investigacionyciencia.es/noticias/un-chip-permite-estudiar-infecciones-bacterianas-crnicas-20289
Want to make a timeline like this?
Use Timetoast to turn dates, events, milestones, and phases into a clear visual timeline you can build and share. Timetoast is a timeline maker for work, school, research, and stories.
